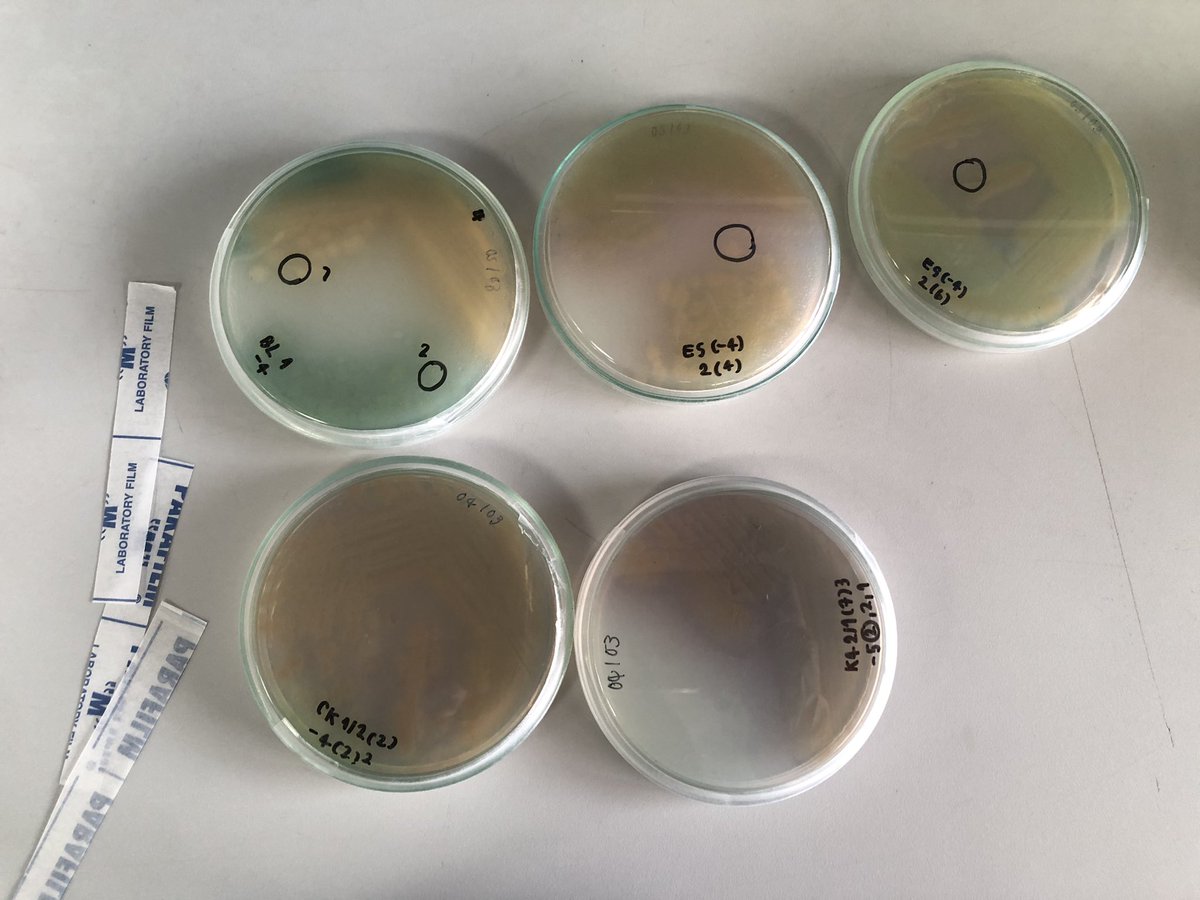
森 tweet media

森
2.9K posts

森 retweetledi
森 retweetledi

เลิศ, เริ่ด, เริ๊ด, เฬิฏ, เฬิฎ, เฬิศ, เฬิษ, เฬิส, เฬิฐ, เฬิษฐ์, เฬิฏฐ์, เฬิธ, เฬิธธิ์, เฬิท, เฬิฑ, เฬิฒ, เฬิจ, เฬิช, เฬิซ, เฬิถ, เฬิศศิ์, เฬิสร์, เฬิ๊ฏ, เฬิ๊ฎ, เฬิ๊ศ, เฬิ๊ส, เฬิ๊ฐ, เฬิ๊จ, เฬิ๊ช, เฦิศ, เฦิฏ, เฦิฎ, เฦิษ, เฦิส, เฦิฐ, เฦิษฐ์, เฦิฏฐ์, เฦิศศิ์, เฦิ๊ศ, เฦิ๊ฏ, เฦิ๊ฎ, เฤิศ, เฤิฏ, เฤิฎ, เฤิศศิ์, เฤิษฐ์, เฤิ๊ด, เฤิ๊ศ, เภิิศ, เภิิฏ, เภิิฎ, เภิิศศิ์, เลิฏ, เลิฎ, เลิษ, เลิส, เลิฐ, เลิษฐ์, เลิศศิ์, เลิ๊ด, เลิ๊ศ, เลิศศศศ, เริ่ดดดด, เฬิศศศศศ, เฦิิศศศศศ, เฬิฏฏฏฏฏ, เฬิฏฐ์เว่อร์, เริ่ดสะบัด, เริ่ดสะมันเตา, เริ่ดแมนแตน, เฬิฏเกินต้าน, เฬิฏแบบตะโกน, เฬิฏศิริ, เฬิธธิ์, เฬิสร์, เล๊ิศ, เล๊ิศศศ, เริ๊ดดดดดดดด, เลิศตระการ, เลิศเลอเพอร์เฟกต์, เลอข่า, เลอข้า, เลอค่าฟ้าจรดทราย, เฬิฏพะยะค่ะ, เฬิฏค๊าาาา, เฬิฏเฟี้ยว, เฬิฏม๊ากกกก, เฬิฏกิงก่องแก้ว, เฬิฏข่ะ, เฬิฏคร่ะ, เฬิฏขร่ะ, เฬิฏฐ์สิริลักษณ์, เฬิฏฐ์โสภณ, เฬิฏฐ์วริศ, เฬิศศศศศศศศศศศศศศศศศศศศศศศศศศศศศศศศ
ไทย
森 retweetledi
森 retweetledi
森 retweetledi
森 retweetledi
森 retweetledi
森 retweetledi
森 retweetledi
森 retweetledi
森 retweetledi

【MANGA】: JUJUTSU KAISEN Spin-off!, JUJUTSU KAISEN Modulo new series now available on MANGA Plus!
✨Read now: mangaplus.shueisha.co.jp/viewer/1026614

Eesti
森 retweetledi
森 retweetledi